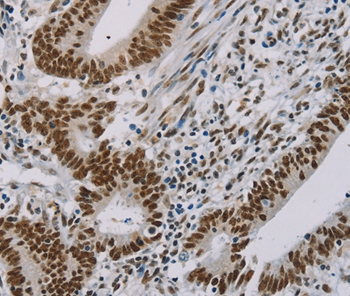

ZMAT3 Antibody (aa58-107)
LS-C81605
ApplicationsWestern Blot
Product group Antibodies
TargetZMAT3
Overview
- SupplierLifeSpan BioSciences
- Product NameZMAT3 Antibody (aa58-107)
- Delivery Days Customer14
- Application Supplier NoteELISA titer using peptide based assay: 1:62500. Western Blot: Suggested dilution at 1 ug/ml in 5% skim milk / PBS buffer, and HRP conjugated anti-Rabbit IgG should be diluted in 1:50000 - 100000 as second antibody.
- ApplicationsWestern Blot
- Applications SupplierWB ELISA titer using peptide based assay: 1:62500. Western Blot: Suggested dilution at 1 ug/ml in 5% skim milk / PBS buffer, and HRP conjugated anti-Rabbit IgG should be diluted in 1:50000 - 100000 as second antibody.
- CertificationResearch Use Only
- ClonalityPolyclonal
- Concentration0.5 mg/ml
- ConjugateUnconjugated
- Estimated Purity...
- Gene ID64393
- Target nameZMAT3
- Target descriptionzinc finger matrin-type 3
- Target synonymsPAG608, WIG-1, WIG1, zinc finger matrin-type protein 3, WIG-1/PAG608 protein, p53 target zinc finger protein, p53-activated gene 608 protein, zinc finger protein WIG1
- HostRabbit
- IsotypeIgG
- Storage Instruction-20°C,2°C to 8°C
- UNSPSC12352203